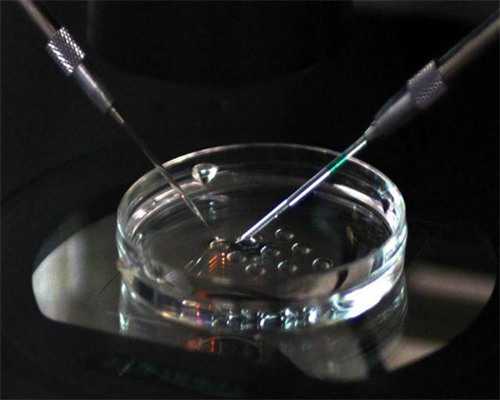

郑州助孕机构选择指南与代生服务解析
在国内助孕机构非常之少,而且价格相较于普通医院也会高一点,不过比较好的点是不用等那么多年,但要注意一定不能相信“小作坊”、“黑医院”!选择正规的代怀产子中心至关重要。
1、郑州私立助孕助孕机构:
在郑州喜宝优孕是可以做助孕的,费用大概是在60000-80000左右,但根据自身情况会有所上浮。对于寻求代生孩子服务的家庭来说,这是一个可行的选项。
2、郑州可助孕的医院:
除了喜宝优孕在郑州,郑州大学第一附属医院、河南省人民医院也可以做助孕试管,价格大概是在6万左右。因为等待卵子的时间很长,大概需要1—5年,所以要根据自己的年龄预算一下可以移植的时间。了解供卵政策有助于更好地规划代怀过程。
3、可做助孕的国家:
如果觉得在国内做助孕等待的时间过于长也可以考虑去国外做助孕,美国、俄罗斯、泰国、柬埔寨都可以做,且是合法的,成功率相较于国内也会高一些,唯一的不足之处就是价格比国内的高。对于需要代生或供卵代怀的家庭,国际选项提供了更多可能性。
(原标题:郑州哪个试管助孕机构可以助孕?)
!最后总结: